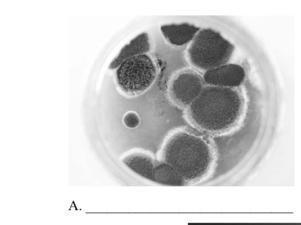

1.3.В приведённом ниже списке даны характеристики объектов живой природы. Все они, за исключением одной,относятся к характеристикам объекта, изображенного в здании 1.1 над буквой. А. Выпишите эту характеристику, которая "выпадает" из общего ряда. Объясните свой выбор ( неограниченный рост, активный образ жизни, клеточное строение, половое размножение)
Приложения:
Ответы
Ответ дал:
8
Активный образ жизни не является характерным для грибов. Он будет присущ животным.
elviraajdamirova:
я не поняла ответ
ответ: активный образ жизни
спасибо
если что это грибы
да, я понял
Вас заинтересует
2 года назад
3 года назад
8 лет назад
10 лет назад